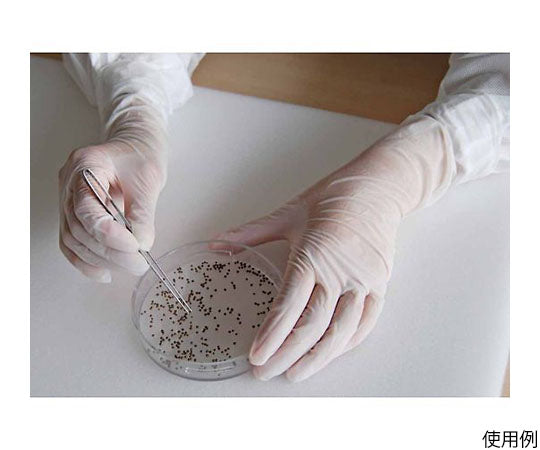
니트릴 스탯(클린 팩) 100장입 S C0710-S 1봉(100장입)

1
/
의
5
ショーワグローブ
니트릴 스탯(클린 팩) 100장입 S C0710-S 1봉(100장입)
니트릴 스탯(클린 팩) 100장입 S C0710-S 1봉(100장입)
정가
¥5,720
정가
할인가
¥5,720
단가
/
단위
배송료는 결제 시 계산됩니다.
픽업 사용 가능 여부를 로드할 수 없습니다.
전체 길이 29cm의 니트릴 고무 제 사용 장갑 100 매입입니다.
이온 오염 (이온성 불순물)이 적은 장갑입니다.
식품 가공 등 식품에 직접 닿는 작업에서도 사용하실 수 있습니다.
정전기 방지 효과가 있습니다.
밀기 쉽게하기 위해 내면 처리를 실시하고 있습니다.
맨손 감각을 살릴 수있는 매우 얇은 타입입니다.
니트릴 고무로 만들어져 내유성이 우수합니다.
클래스 100으로 포장한 클린 룸 대응품입니다.
좌우 겸용 타입입니다.
파우더 프리 타입입니다. 크기: S
색상: 화이트
소재:수지부/합성 고무(니트릴 고무)
전체 세부 정보 보기